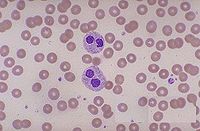
Bk33m.jpg

凝血因子
| A+医学百科 >> 凝血因子 |
凝血因子是参与血液凝固过程的各种蛋白质组分。它的生理作用是,在血管出血时被激活,和血小板粘连在一起并且补塞血管上的漏口。这个过程被称为凝血。它们部分由肝生成。可以为香豆素所抑制。为统一命名,世界卫生组织按其被发现的先后次序用罗马数字编号, 有凝血因子Ⅰ,Ⅱ,Ⅲ,Ⅳ,Ⅴ,Ⅶ,Ⅷ,Ⅸ,Ⅹ,Ⅺ,Ⅻ,Ⅻi等,因子XIII以后被发现的凝血因子,经过多年验证,认为对于凝血功能,无决定性的影响,不再列入凝血因子的编号。因子 VI 事实上是活化的第五因子,已经取消因子VI的命名。
目录 |
主要凝血因子
因子 I, 纤维蛋白原
因子 II, 凝血素
因子 III, 凝血酶原酶
因子 IV, 钙(Ca2+) 因子
因子 V, 促凝血球蛋白原,易变因子
因子 VII, 转变加速因子前体,促凝血酶原激酶原,辅助促凝血酶原激酶
因子 VIII, 抗血友病球蛋白A (AHG A), 抗血友病因子A (AHFA),血小板辅助因子 I, 血友病因子 VIII 或 A,
因子 IX, 抗血友病球蛋白B (AHG B),抗血友病因子B (AHF B),血友病因子 IX 或 B
因子 X, STUART(-PROWER)-F, 自体凝血酶原C
因子 XI, ROSENTHAL因子,抗血友病球蛋白C
因子 XII, HAGEMAN因子, 表面因子
因子 XIII, 血纤维稳定因子
辅助凝血因子
FITZGERALD因子
FLETCHER因子 (激肽释放酶原)
von-Willebrand-因子
被取消资格的凝血因子
因子 VI, 促凝血球蛋白:其实是活化后的第五因子。
这些因子共同作用,会导致凝血。
如果一种或多种凝血因子缺失,会导致“血友病”: 血液病,血友病。
同义语 缩写符号 血浆浓度 在血清中 贮存稳定性 参与凝血途径
Ⅰ 纤维蛋白原 Fg 2000-4000 无 稳定 共同
Ⅱ 凝血酶原 200 有10%-12% 稳定 共同
Ⅲ 组织凝血激酶 TF 外源
Ⅴ 前加速素 5-10 无 不稳定 共同
Ⅶ 前转变素 2 有 稳定 外源
Ⅷ 抗血友病因子 AHG 〈10 无 不稳定 内源
Ⅸ 血浆凝血激酶 PTC 3-4 有 较稳定 内源
Ⅹ Stuart Power因子 6-8 有 稳定 共同
Ⅺ 血浆凝血激酶前质 PTA 4 有 稳定 内源
Ⅻ 接解因子 HF 2.9 有 稳定 内源
PK 激肽释放酶原 PK 1.5-5.0 有 稳定 内源
HMWK 高分子量激肽原 HMWK 7 有 稳定 内源
ⅩⅢ 纤维蛋白稳定因子 FSF 25 无 稳定 共同
临床应用
通常认为PT延长代表凝血因子Ⅱ、Ⅴ、Ⅶ、Ⅹ的活性低于正常或抗凝物质的存
在。肝功能轻度受损,PT仍可正常,它仅在肝实质细胞严重损害时才明显延长。仅
以PT判断肝病患者凝血功能异常和肝细胞损伤程度是不够的,如同时测定凝血因子
的活性,可能更有价值。
大多数研究认为急性肝炎和慢性肝炎轻度患者,凝血因子Ⅱ活性正常或轻度下
降;慢性肝炎中度、重度和肝硬化患者,凝血因子Ⅱ活性水平明显下降,说明它的
降低程度与肝细胞损害程度密切相关。有研究认为异常凝血酶原(protein-Ⅱin
ducedbyvitaminKabsence,PIVKA-Ⅱ)可用于原发性肝癌的诊断,部分AFP阴
性的原发性肝癌患者PIVKA-Ⅱ阳性,还有研究认为小肝癌患者PIVKA-Ⅱ阳性率高于
AFP[8],它还有助于原发性肝癌的病情变化及疗效判断[9],在临床上应联合检测
AFP与PIVKA-Ⅱ。
研究显示凝血因子Ⅴ活性在肝功能失代偿或严重肝病时才减少,故认为它是判
断肝病患者预后的良好指标。Izumi等[10]研究显示:对乙酰氨基酚诱导的需肝移
植的暴发性肝功能衰竭患者,凝血因子Ⅴ活性<20%时对死亡的阳性预测值为0.49,
<10%时为0.57;而其它原因诱导的需肝移植的暴发性肝功能衰竭患者,凝血因子Ⅴ
活性<20%时对死亡的阳性预测值为0.85,<10%时为1.00,因此认为凝血因子Ⅴ活性
是判断非对乙酰氨基酚诱导的暴发性肝功能衰竭患者预后的最佳预测指标。邹正升
等[11]研究认为凝血因子Ⅴ水平比PTA更特异的反映重型肝炎患者的预后,两者联
合可能有助于更早更准确诊断重型肝炎,同时指出应加强重型肝炎因子Ⅴ的检测及
重视因子Ⅴ在作为肝衰竭患者行肝移植术时的主要筛选指标的研究。凝血因子Ⅴ活
性除用于判断预后外,还与血栓的形成密切相关,可作为门静脉血栓形成的预测指
标。
凝血因子Ⅶ的半衰期最短(4~6h),血浆含量较低(0.5~2mg/L),故可作
为肝病患者蛋白质合成功能减退的早期诊断指标。Rodriguez-Inigo等[12]在慢性
肝病患者通过肝活检组织原位杂交的方法检测到凝血因子Ⅶ的表达与肝纤维化的分
级呈负相关,可作为预测纤维化程度的指标。凝血因子Ⅶ活性还与预后有着密切的
联系,如Violi等研究认为凝血因子Ⅶ活性<34%的肝硬化患者93%在随访10月内死亡
,故认为它是肝硬化患者预后好坏的早期预测指标,可更好识别肝移植候选人。肝
硬化患者凝血因子Ⅶ活性可明显下降,凝血因子Ⅶ缺乏可导致血小板活性的改变,
结合血小板计数减少使出血时间延长,因此对有创诊断与治疗的肝硬化患者,还应
该用凝血因子Ⅶ活性进行出血危险度的评估,而不能仅看血小板计数[13]。除诊断
之外,重组凝血因子Ⅶ可以有效地纠正肝病患者凝血异常,有利于有创性检查的进
行[14]。
凝血因子Ⅷ不仅由肝细胞产生,而且由窦内皮细胞与库普弗细胞产生,其它组
织如肾脏也可产生。当肝细胞合成功能减退时,窦内皮细胞及库普弗细胞仍维持凝
血因子Ⅷ的合成;肝脏清除功能减退,内毒素及免疫因素刺激使它的合成与释放增
加[15]。范威氏因子(vonwillebrandfactor,vWF)主要由肝外合成,肝硬化患
者可能由于内毒素血症,血管内皮细胞功能异常,使其释放增加;vWF分解蛋白酶
对其分解减少,也使其血浆水平升高。在大多数病毒性肝炎患者凝血因子Ⅷ活性、
vWF均明显升高。但肝病合并DIC者,由于凝血因子大量消耗,使凝血因子Ⅷ活性
水平降低,故我国将凝血因子Ⅷ活性小于正常50%作为诊断肝病合并DIC的必备条件
之一。
参与血液凝固过程的各种组分;其中大多是含糖的丝氨酸蛋白酶。整个凝血过程大致上可分为两个阶段,凝血酶原的激活及凝胶状纤维蛋白的形成。
凝血酶原激活
体内存在有内源性及外源性两种激活系统。前者是指心血管内膜受损,或血液流出体外通过与异常表面接触而激活因子Ⅻ(Hageman factor)。后者则由于组织损伤释放出因子Ⅲ,从而激活因子Ⅶ。两者都能启动一系列连锁反应,并在因子Ⅹ处汇合,最后都导致凝血酶原的激活及纤维蛋白的形成。
内源性激活系统
整个凝血酶的激活途径如图1所示。当血液与带负电荷的胶原蛋白(皮肤血管外壁)或异体表面(如高岭土、玻璃等)接触时,因子Ⅻ就由酶原激活成Ⅻa,后者除能激括因子Ⅺ外,又同时使血浆前舒缓激肽释放酶激活。激活后的激肽释放酶在高分子量激肽原的促进下反过来又进一步使因子Ⅻ激活,但此时不再是接触激活而是肽键水解激活(见蛋白水解酶),使成为因子Ⅻf。这是一正反馈效应,不论Ⅻa或Ⅻf都具有相同的活力。激活后的Ⅻa在Ca2+存在下接着又使因子Ⅸ激活。 因子Ⅻ是由596个氨基酸残基所组成,因子Ⅺ是由两个亚基所组成,每一亚基含607个氨基酸残基,其结构与血浆激肽释放酶很类似。
因子Ⅸ由416个氨基酸残基所组成,激活时释放出一肽段,形成由二硫键连结的两条肽链。与磷脂结合的部位在轻链,而酶的催化活性部位则在重链。活化的因子Ⅸa在Ca2+与磷脂存在下与因子Ⅷ形成复合物,使因子Ⅹ激活为因子Ⅹa。在正常生理条件下磷脂由血小板提供,在此反应中因子Ⅸa起酶催化作用,而因子Ⅷ只是起调节作用,由于它也能与因子Ⅹ结合,从而使局部的底物浓度增高。事实上单独因子Ⅸa也能使因子Ⅹ激活,但在因子Ⅷ参与下反应速度可增加数千倍以上。因子Ⅷ还需有因子Ⅹa及凝血酶的激活而成为因子Ⅷ',这里也是一正反馈效应。因子Ⅷ是一分子量达百万以上的糖蛋白,高盐浓度下解离成分子量约20万的亚基。若体内由于基因缺陷,因子Ⅷ欠缺或无活性,在临床上就表现出先天性血友病。因此因子Ⅷ又称为抗血友病因子。
因子Ⅹ是由448个氨基酸残基所组成,激活时释放出一肽段,形成由二硫键连结的两条肽链。它与因子Ⅸ相似,与磷脂及因子Ⅴ的结合部位在轻链,而酶的催化活性部位在重链。
激活后的因子Ⅹ与Ca2+、磷脂及因子Ⅴ共同形成一复合物,后者最终使凝血酶原激活为凝血酶。因子Ⅴ的性质与因子Ⅷ有很多相似之处,它不是起酶的催化作用,而是加速凝血酶原的激活,当因子Ⅴ与磷脂同时存在时激活过程可加速2万倍。 同样因子Ⅴ也可被凝血酶激活成Ⅴ',成为另一正反馈效应。因子Ⅴ也是一大分子量的糖蛋白,由分子量约30万的亚基所组成,在体内极不稳定,容易被体内蛋白C(也是一种丝氨酸蛋白酶)所破坏,因此称为不稳定因子。
凝血酶原(即因子Ⅱ)由 581个氨基酸残基所组成,当被因子Xa复合物激活时,几乎同时在肽键Arg(精274)-Thr(苏275)及Arg(精322)-Ile(异亮323)处水解,并自N端释放出分子量约3万的肽段(残基1~274),形成由两条肽链通过二硫键连接的凝血酶。激活后的凝血酶又能催化降解凝血酶原,在残基Arg(156)-Ser(157)处的肽键水解,释放出A肽段并形成新凝血酶原-S,后者就不易再被Xa所激活。有人认为片段A通过Ca2+及磷脂与因子Xa相结合,如果此肽段被水解除去后,新凝血酶原-S就丧失与因子Xa结合的能力,即使它仍含有可被因子Χa专一水解的肽键,反应也极不易进行。这是凝血酶原激活过程的一个重要的负反馈调节机制,避免了体内由于产生过量凝血酶而引起血栓。
当凝血酶原激活时从N端释放的肽段,大致上可分为两个区域,即A肽段(残基1~156)及S-肽段(残基157~274)。此两肽段在氨基酸组成上特别是二硫键的位置非常相似,其中有31个氨基酸残基完全相同,在构型上似乎各自成为独立的单位,被称为“环饼”结构。一般认为此两环形结构能分别与因子Xa相结合,因而可在两个肽键处(残基274~275,322~323)同时水解而激活成凝血酶。 如果只有残基 274处的肽键被因子Xa水解,生成的新凝血酶原-T则不能再激活成凝血酶。
外源性激活系统
体内组织损伤时释放出因子Ⅲ,也称为组织因子。 在Ca2+存在下它能与血液中已活化的因子Ⅷ形成复合物,就能使因子Ⅹ激活,此后就与内源性激活途径的反应步骤相同。通过外源性途径血液凝固在10多秒钟内即可完成,而通过内源性途径则需数分钟。
因子Ⅲ为一膜糖蛋白,由263个氨基酸残基所组成,存在于血管内皮细胞,分布于体内各组织,在肺、脑、胎盘中更丰富。如果细胞膜受到损失它就随之释放。因子Ⅲ的作用类似于因子Ⅷ及Ⅴ,也是调节因子,不同的是,由于存在于膜上,因而无需血小板的磷脂参与。因子Ⅶ激活因子Ⅹ的机理类似于因子Ⅸ。上述内源或外源系统中各凝血因子Ⅻ、Ⅺ、Ⅸ、Ⅹ、Ⅶ,凝血酶以及与凝血系统有关的激肽释放酶、蛋白C都属于丝氨酸蛋白酶,它们活性部位附近的氨基酸排列顺序都与胰蛋白酶极为相似,不同的是它们都是糖蛋白。
因子Ⅶ是由406个氨基酸残基所组成,激活时不释放出肽段,其结构与因子Ⅸ、Ⅹ很相似。
凝血因子与维生素K 在凝血酶原近N端的肽段中有一种特殊氨基酸,即γ-羧基谷氨酸。由于在同一谷氨酸侧链中含有两个羧基,与Ca2+的亲合力就特别强。这样,凝血酶原就可通过Ca2+再与磷脂结合,这是因子Ⅹ激活凝血酶原所必需的。若动物给以维生素K的拮抗剂,如双羟香豆素,则在凝血酶原分子中原有的γ-羧基谷氨酸残基又被正常谷氨酸所取代,同时凝血机能也受到损害,由此认为维生素K是作为γ羧化酶的辅酶,在凝血酶原分子中总共有10个γ-羧基谷氨酸,它们都集中于N端32个氨基酸残基的肽段上(图3)。这就不难理解,一旦A肽段被凝血酶自身降解而除去后,留下的新凝血酶S就很难再被因子Ⅹa所激活。除凝血酶原外其他与维生素K有关的凝血因子还有因子 Ⅸ、Ⅹ及Ⅶ,还包括使因子Ⅴ、Ⅷ失活的蛋白C。它们在N端肽段附近都有类似的顺序,γ-羧基谷氨酸的位置也都不变,激活后都形成两条链,轻链为N端部分,含有γ-羧基谷氨酸,因而能与Ca2+及磷脂相结合。 重链为C端部分,含有酶的催化中心。
纤维蛋白的形成
从纤维蛋白原转变为纤维蛋白大致上可分为三个阶段:
纤维蛋白单体的形成
纤维蛋白原(因子Ⅰ)为一分子量约34万的糖蛋白,
是由两个完全相同的亚基所组成,每一亚基又含有三条肽链,即α、β、γ 链,彼此通过二硫键相互连接。此三条肽链分别含610、461及410个氨基酸残基。 两个亚基在肽链N端附近再通过三对二硫键将对称的二亚基连结起来(图4)。因此整个纤维蛋白原分子可用 (Aα,Bβ,γ)2来表示,A、B分别代表被凝血酶自α、β肽链N末端水解释放的肽段,形成纤维蛋白后则用(α、β、γ)2来表示。在纤维蛋白分子中二硫键的位置相当集中,存在有所谓“二硫键节”的结构,其位置也靠近肽链的N端(图4)。β与γ肽链的氨基酸顺序很相似,特别近C端附近约有1/3是相同的。有人根据纤维蛋白原的理化性质提出了图5 的模型,球体间的连接部分即为螺旋区,由三条肽链形成绳索状的螺旋结构。 肽链C端球体的大小与形状类似血浆白蛋白,结构较紧密,并连接一条松散的α链C端肽段,容易被纤溶酶或其他蛋白酶所降解。
当凝血酶作用于纤维蛋白原时首先自 α链的 N端处释放出一16肽的肽段A,经过一滞后期后自β链的N端开始加速释放出一14肽的肽段B,剩下的部分即为纤维蛋白的单体。不同种属的纤维蛋白原A、B肽段的水解位置都在Arg(精)-Gly(甘)肽键上。肽段A、B的氨基酸组成可因不同种属而有很大差异,但都带有2~6个负电荷,并含有某些特殊氨基酸,如肽段A中含有带磷酸基的丝氨酸,肽段B中含有带硫酸基的酪氨酸。正因为肽段A、B带有净负电荷,使纤维蛋白原分子在未经凝血酶降解前,由于静电相斥而不能聚合。
纤维蛋白单体的聚合 在纤维蛋白单体的聚合过程中肽段A的释放起主要作用,先是首尾聚合,而肽段B的释放能使聚合加速并开始侧向聚合。纤维蛋白单体由于A、B肽段的释放,在每一亚基中暴露出两个相嵌的互补区,单体间就可藉非共价键首尾或侧向聚合,随着侧向聚合程度加深,血块显得粘稠,由透明转向不透明。
纤维蛋白的交联
激活后的凝血酶除降解纤维蛋白原释放肽段A、B外,
在Ca2+存在下又同时迅速使因子ⅩⅢ激活,后者能使聚合的纤维蛋白在邻近的肽链间形成桥键,而成为稳定而交联的纤维蛋白多聚体,即使在5M尿素溶液中也不溶解,而交联前的凝胶在此条件下则可溶解。因子ⅩⅢ为转谷氨酰胺酶,它使肽链间赖氨酸残基上的ε氨基与谷氨酰胺残基上的γ酰胺基连结成新的肽键。每一纤维蛋白单体最多能形成6个共价桥键,若每分子内有2~3个,就可形成很稳定的交联纤维蛋白。
长期的进化使纤维蛋白原成为理想的止血剂,如在未激活前分子间由于静电相斥不能聚合而成为溶胶;位于肽链N端的A、B肽容易被凝血酶水解除去,随之静电效应消失,凝胶迅速形成;在肽链C末端附近又可再形成桥键,使成为稳定的凝胶并有足够的机械强度;分子量大,亲水性强、呈对称性,符合凝胶特性;分子中含一段绳索状螺旋结构区,容易被蛋白酶降解,在体内不致于形成血栓;纤维蛋白凝胶的降解产物具有抑制凝血酶的活力,也能阻止纤维蛋白单体的聚合,从而起到自身调节的反馈作用。
在凝血体系中除了各因子间的正负反馈及自身调节外,属于蛋白酶的凝血因子又受血浆中相应的蛋白酶抑制剂的制约,例如血浆中的抗凝血酶Ⅲ(ATⅢ,antithro-mbinⅢ),除能专一抑制凝血酶外,还能抑制因子Ⅹa、Ⅸa、及Ⅶa,特别对Ⅹa的抑制效果尤其显著。肝素能大大加速AT-Ⅲ的抑制作用,因而在临床上被用作重要的抗凝剂。除AT-Ⅲ外血浆中还有其他蛋白酶抑制剂,如α1抗蛋白酶、抗纤溶酶及α2巨球蛋白等,它们对凝血因子中的各蛋白酶也都有一定程度的抑制作用。
| 血液 |
|---|
| 白血病 和 白血球 |
| 淋巴系统: 淋巴性白血病 (急性, 慢性) | 淋巴瘤 (霍奇金淋巴瘤, 非霍奇金淋巴瘤) | 淋巴增生 | 骨髓癌 (多发性骨髓癌, 质浆细胞瘤) |
| 骨髓: 骨髓性白血病 (急性, 慢性) | 骨髓增殖性疾病 (原发性血小板增多症, 红血球增多症) | 骨髓成形不良症候群 | 骨髓纤维化 | 嗜中性白血球过低症 |
| 红血球 |
| 贫血 | 血色病 | 镰状细胞贫血 | 地中海贫血 | 溶血性贫血 | 再生不良性贫血 | 蚕豆症 | 遗传性球形红细胞增多症 | 遗传性椭圆形红血球增多症 | 其他血红蛋白病 |
| 凝血因子和血小板 |
| 血栓形成 | 深静脉血栓形成 | 肺栓塞 | 血友病 | 自发性血小板缺乏紫斑症 | 血栓性血小板缺乏紫斑症 | 弥散性血管内凝血 |
| 关于“凝血因子”的留言: | |
给凝血因子条目的留言--110.243.136.169 2020年5月9日 (六) 14:02 (CST) 留言:II因子是凝血酶原,和凝血素不一样吧 | |
| 添加留言 | |